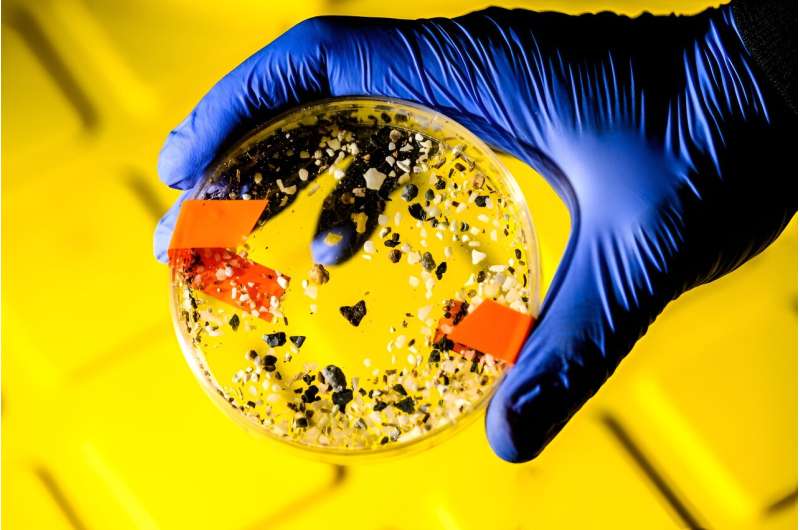
Microplastics Impede Ocean s Carbon Sequestration – A Climate Crisis Threat

It turns out plastics in the ocean do more than suffocate turtles, fish and other marine life.
A new study co-authored by Northeastern researcher Aron Stubbins shows that microplastics may reduce the ability of the ocean to help offset the climate crisis by slowing down the rate at which carbon is taken from the sea surface to the depths.
For millennia, the ocean has been part of a carbon sink process in which dead phytoplankton clump together and fall into the deep ocean in showers of what look like "marine snow," says Stubbins, a professor of marine and environmental science.
The resulting carbon sequestration is a marine version of how trees and plants on terrestrial Earth take carbon from the atmosphere and store it in soil, he says.
But research by Northeastern shows that microplastics in the ocean are slowing the process down by making the "marine snow" more buoyant, Stubbins says.
"Plastics want to float. If phytoplanktons grow on microplastics in biofilms, instead of as free living organisms, that changes the buoyancy of the phytoplankton when they die," Stubbins says.
"Basically, the plastics are slowing down the sinking rate of the marine snow, which is potentially reducing the efficiency with which the ocean can remove carbon dioxide from the atmosphere," he says.
For the study reported in Marine Chemistry, researchers grew the tiny one-celled plankton in tanks with and without exposure to microplastics.
Then they held their own version of a race to the bottom.
The researchers put the regular clumps of phytoplankton in one measuring cylinder filled with seawater and put the phytoplankton entwined with microplastics in another cylinder.

"You timed how quickly they sank," Stubbins says. "The ones with the plastics were slower, by about 20%."
He says the study, done in collaboration with the University of New Hampshire, shows the slowing of the descent rate of marine snow mixed with microplastics comes at a time when carbon sequestration is more important than ever.
"As that carbon is sinking it is being transported deeper into the ocean," Stubbins says. "It is so important for how much the ocean offsets warming due to human emissions of carbon dioxide."
A second part of the study involving Ariana Patterson, who graduated from Northeastern in 2023, found that microplastics dissolving in sunlight on the ocean surface reduce nutrient availability for phytoplankton.
When exposed to sunlight, the microplastics dissolve like sugar cubes and produce organic carbon that bacteria can use as food, Stubbins says. But growing bacteria also need nitrogen and phosphorus and they can get it by stealing the nutrients from phytoplankton and slowing their growth.
"Phytoplankton are plants of the sea—they are the ones capturing carbon from the atmosphere. So, by adding plastic carbon, you further reduce the efficiency of the biological carbon pump," he says.
"Today, we find microplastics everywhere. Concentrations in the ocean continue to increase," Stubbins says.
"We're finding that it could be a threat to global scale processes, such as the carbon cycle that is so important for all life," he says.
Scientists still don't have enough information to say definitively that the presence of microplastics will weaken the ocean's ability to sequester carbon or what a critical level of microplastics might be, Stubbins says.
But he says the study shows that the impact of microplastics on the carbon cycle "is significant enough to create some alarm and suggest we should think about it carefully."
More information: Kai Ziervogel et al, Microbial interactions with microplastics: Insights into the plastic carbon cycle in the ocean, Marine Chemistry (2024). DOI: 10.1016/j.marchem.2024.104395
Provided by Northeastern University
This story is republished courtesy of Northeastern Global News news.northeastern.edu.